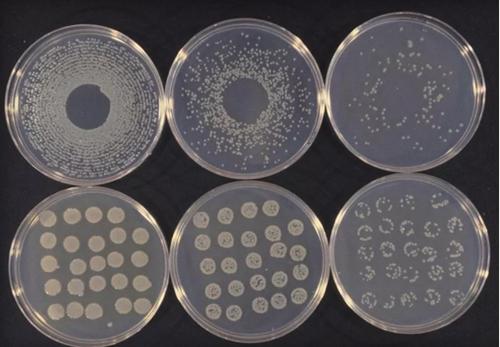
甜樱桃轮纹病,甜樱桃根腐是什么原因

点击右上角「关注」,掌握更多种植技术!实现丰产丰收!
*今条头日**的朋友们大家好!今天要给大家讲的是樱桃,甜樱桃在我国很多地区都有种植,如四川,山东,辽宁,河南等地区。而在我国樱桃主产区中,樱桃流胶病相对其他病害来说,不仅发病言范围广而且危害大,严重影响到樱桃产量和质量,甚至死枝毁树,减产绝收。所以防治流胶病,是一场攻坚战,不能掉以轻心!

专家交流流胶病
樱桃流胶病到底是什么病?
以前大家都认为樱桃流胶病是由剪锯口、虫口以及涝害、冻害、干旱等因素引起的生理病害。
后来美国康奈尔大学和纽约州立农业试验站发现引起樱桃流胶的主要致病菌是丁香假单胞菌和细菌性溃疡病菌,樱桃流胶病是一种细菌性病害!康奈尔大学的权威信不言而喻,于是国内开始用杀菌剂去防治,有些地区能治好,有些地区不能治好。这就是一件怪事了,但任何一件怪事都有它的科学逻辑,一定是我们还没有发现它的规律。
丁香假单胞菌 图片来自:http://www.theverge.com/
为了摸清烟台地区樱桃流胶病的致病原因,国家公益性行业樱桃科研专项项目组采集了33个大樱桃流胶病样本,发现该地区引起樱桃流胶病的有7种真菌,其中贝伦格葡萄座腔菌和细极链格孢菌为主要致病菌,出现的频率分别为33.33%和28.57%(数据来源:张福兴,董向丽,潘凤荣,孙庆田.甜樱桃流胶病研究综述[J].烟台果树,2015(03):1-5.),确定了烟台及其周边地区引起大樱桃流胶的致病因子是真菌。

葡萄座腔菌
以上两个研究案例,说明樱桃流胶病可能是细菌引起的,也可能是真菌引起的,不同地区可能会存在差异。大量文献中对樱桃流胶病的主流观点,人为引起樱桃流胶病的是葡萄座腔菌和丁香假单胞菌(参考文献:①Elizabeth A.Botryosphaeria canker and dieback of trees and shrubs in the landscape [J].Virginia Cooperative Extension:450-726.
②Vries D P. Field resistance to bacterial canker in some cherry seedling populations[J].Euphutica,1965,14:78-82.)。
所以根据发病原因,可以把樱桃流胶病可分为非侵染性和侵染性2种类型,非侵染性指生理性流胶病,发病部位主要是主干和主枝,有时小枝也会发病,表现为病部肿胀,病部流出半透明的黄色树胶。果实发病会分泌黄色胶质。侵染性流胶病主要是葡萄座腔菌和丁香假单胞菌引起的,病部枝干皮层呈疣状隆起,或以皮孔为中心出现凹陷病斑,从皮孔渗出胶液,在枯死的枝干附近抽生的新梢上可能有小黑粒点状突起物。所以摸清了樱桃流胶病是什么病,我们才能对症下药!

樱桃流胶病
为什么会出现樱桃流胶病?
就像人生病了一样,比如牙疼去看医生,医生给你开了药说要早晚刷牙,不要吃太冷的东西刺激牙齿。我们就知道你牙疼可能是因为不注重口腔卫生引起的。那么樱桃流胶病呢?是什么样的环境创造出了细菌和真菌的温床?主要有4点,分别是湿度与温度、土壤条件、品种与砧木和树体伤口。
- 湿度与温度
樱桃流胶病在整个生长期都有可能发生,与温度、湿度关系密切。春季温度上升、雨水多,可能会出现流胶病,连续阴雨天气会加剧樱桃树的病情,因为雨水很容易把病原菌传播到皮孔和伤口部位,从而扩散。伤口与皮孔是病原菌入侵的主要途径,其中伤口更有利于病原菌的入侵。随着气温降低与降水量减少,流胶病情况会有所减缓。
- 土壤条件
果园土质蓬松、具有较高的有机质含量、排水条件好且养分充足,不容易出现流胶病。酸性、透气性较差及种植过樱桃的土壤流胶病容易发生。偏施氮肥、负载量过大、地势低洼、雨季排水不畅的地块发病严重。
- 品种与砧木
不同品种、砧木抗流胶病的能力是不同的。根据潘风荣等调查,发现红艳的抗流胶能力最强,美早、红灯、巨红、雷尼、8-102次之,红蜜抗流胶病能力最差(下图)。

不同品种抗流胶病能力
此外,马哈利、本溪山樱为砧木的红灯抗流胶病能力较强,以大叶草樱为砧木的次之,以莱阳矮樱为砧木的最差(下图)。

不同砧木抗流胶病能力
- 树体伤口
吉丁虫、红颈天牛、桑白蚧等病虫会使樱桃树树干出现伤口,从而引发樱桃树流胶病。致病菌由于霜降、冻伤、日灼上与机械损伤等而获得了入侵的途径,从而增加了流胶病病发率。
如何防治樱桃流胶病?
其实,对于樱桃流胶病的研究还处于探索阶段,流胶病防治效果并不好,没有从根本上找到有效的防治方法,植物病害诱抗剂的出现,为植物病害的防治提供了一条可行途径。在此介绍一下,为大家提供参考。石忠强等用5种诱抗剂处理感病樱桃树,发现水杨酸的防治效果比较好。水杨酸相对防治效果为53.7%(数据来源:石忠强,罗珺,缪福俊,王柯人,丁雅迪,王宏虬.樱桃流胶病最适诱抗剂的筛选试验[J].西部林业科学,2015,44(02):157-160.)。用浓度为0.12毫升/升的水杨酸每5天进行一次叶面喷施,连续喷施30天。

对于樱桃流胶病的防治,还是要以预防为主的。首先要加强土肥水管理,樱桃起垄栽可以减轻流胶病的发生。其次科学修剪,保护伤口,对已发生流胶的枝干,要及时刮除流胶病疤,伤口涂抹1. 6%噻霉酮水剂2倍液、40%氟硅唑200倍、21%的过氧乙酸5倍液或灰铜制剂。
需要注意的是,虽然流胶病在春季爆发,但是预防工作的重心要放在秋冬季,把病菌杀死在摇篮里!因为流胶病病菌一般在晚秋和冬季开始侵染,早春形成溃疡组织。12月至次年1月之间清园,去除流胶硬块和坏死组织,修剪枯枝,清扫落叶,地面喷洒石硫合剂。在早春休眠期与秋季落叶期喷洒3~4次农用链霉素和铜制剂,预防和降低初次侵染。
以下是具体用药方案参考:
在萌芽前喷布石硫合剂或40%氟硅唑500倍、21%菌之敌(过氧乙酸)100倍、5%辛菌胺(菌毒清)50倍液;在采果后结合防治叶部病害,喷2~3次40%的氟硅唑4000倍,10%苯醚甲环唑2000倍,25%吡唑醚菌酯2500倍。喷药时,把主干、主枝喷湿、喷匀;在秋季落叶前,喷铜制剂如波尔多液或喹啉铜200倍,共喷2~3遍。
总结
樱桃流胶病相对其他病害来说,不仅发病言范围广而且危害大,严重影响到樱桃产量和质量,甚至死枝毁树,减产绝收。根据发病原因,可以把樱桃流胶病可分生理性流胶病和侵染性流胶病,后者主要是葡萄座腔菌和丁香假单胞菌引起的。要加强土肥水管理,科学修剪,保护伤口,预防工作的重心要放在秋冬季。